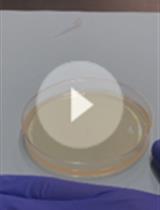
奇异变形杆菌被领土排斥后生长恢复测定和基于FACS的群体分类

发布: 2020年09月05日第10卷第17期 DOI: 10.21769/BioProtoc.3736 浏览次数: 5826
评审: Gisela Di VenanzioGunjan MehtaXiaofeng Zhou
Abstract
Contact-dependent interbacterial competition is a common strategy used by bacteria to fight for their ecological niches. Interbacterial competition is monitored by a competition assay involving co-culturing the attacker and the recipient bacterial cells on agar, followed by recovery of the surviving recipient cells. Conventional interbacterial competition assays rely on serial dilution, plate spreading, and colony counting experiments for the readout. The high demand for time and labor in a competition assay limits its use for large-scale screening. However, a high-throughput interbacterial competition screening method is required to screen genetic factors involved in an interbacterial competition. Here, using Agrobacterium tumefaciens as an attacker and Escherichia coli as a recipient, we developed a robust, fast, efficient, and high-throughput type VI secretion system-dependent interbacterial competition screening platform. This system allows for 96 simultaneous competition assays without the need for serial dilution and plate spreading. Data analysis of this system relies on only direct and straightforward colony counting. This platform may be easily adapted to identify novel factors involved in any contact-dependent interbacterial competition systems.
Keywords: Competition assay (竞争分析)Background
Bacteria have evolved multiple strategies to fight other bacteria to gain ecological niche fitness, and contact-dependent interbacterial competition is one of the widely used strategies (Granato et al., 2019). A bacterium can use its type I (T1SS), type IV (T4SS), type V (T5SS), type VI (T6SS), or type VII (T7SS) secretion systems to deliver protein toxins into its competitor cell, the recipient cell, and kill it in a contact-dependent manner (Aoki et al., 2005; Hood et al., 2010; Souza et al., 2015; Cao et al., 2016; García-Bayona et al., 2017). The protein toxin-delivering bacterium is the attacker cell. The attacker cell also expresses the cognate immunity protein to protect itself from self-intoxication. A competition assay can measure the strength of a contact-dependent interbacterial competition. A competition assay can be divided into four steps: (1) culturing the attacker and recipient cells, (2) preparing the competition spot by mixing the two bacterial strains and incubating it on an agar plate, (3) recovery and selective growth of the recipient cells from the competition spot, and (4) counting the colony-forming units (CFUs) of the surviving recipient cells. The attacker with a robust interbacterial competition activity results in low recipient CFU.
Although the competition assay is a straightforward experiment, a high-throughput platform for 96 parallel competition assays is lacking. Several factors limit the capacity of a competition assay. First, each competition spot has to be separated at a distance to avoid cross-contamination during the recovery step. The need for the separation hinders the competition spots from arranging compactly, as in a 96-well format. Second, the recovery step and also the CFU counting step are time-consuming and laborious. In the recovery step, each competition spot is collected by an inoculating loop. Recording the CFU of the recipient cell requires serial dilution and plate spreading.
Here we present a high-throughput interbacterial competition platform that performs 96 competition assays simultaneously and does not require serial dilution and plate spreading. In this platform, the 96 competition mixtures were spotted on an agar plate solidified on a 96-well lid and recovered by a 96-pin microplate replicator instead of an inoculating loop. Using a 96-pin microplate replicator ensures that equal amounts of the bacteria are recovered, which is equivalent to the area of each pin. Because this method minimizes the amount of recovery to the pin area, serial dilution and plate spreading are not required. Meanwhile, the readout of this platform is direct and straightforward by counting the CFU of the recipient cells. This platform has been used to identify the recipient factors that are involved in enhancing the T6SS activity of Agrobacterium tumefaciens with success (Lin et al., 2020). We tested all 3,909 E. coli Keio mutants for their recovery after co-incubation with a T6SS active A. tumefaciens strain within 1 month. This method can be used to screen for both the attacker and recipient mutants with enhanced or reduced interbacterial competition activity mediated by any secretion system.
Materials and Reagents
Equipment
Software
Procedure
文章信息
版权信息
© 2020 The Authors; exclusive licensee Bio-protocol LLC.
如何引用
Lin, H. and Lai, E. (2020). A High-throughput Interbacterial Competition Platform. Bio-protocol 10(17): e3736. DOI: 10.21769/BioProtoc.3736.
分类
微生物学 > 微生物生理学 > 种间竞争
微生物学 > 微生物信号传导 > 种间交流
您对这篇实验方法有问题吗?
在此处发布您的问题,我们将邀请本文作者来回答。同时,我们会将您的问题发布到Bio-protocol Exchange,以便寻求社区成员的帮助。
Share
Bluesky
X
Copy link